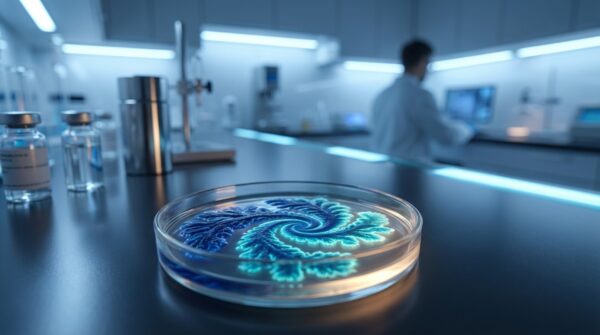
תמונה מדעית הממחישה את המיקרוביום של העור וטיפול פרוביוטי באקנה.

בדיקת ביוץ חיובית? המדריך המלא: מתי לקיים יחסים ואיך קסימינל מסייע
הרגע הזה שבו מופיעים שני פסים ברורים על מקלון בדיקת הביוץ הוא רגע מלא בתקווה, התרגשות, ולעיתים גם בלבול. קיבלת בדיקת ביוץ חיובית, וזהו איתות נפלא מהגוף שלך. אבל מה עכשיו? מתי בדיוק הזמן הנכון לקיים יחסים כדי למקסם את הסיכוי להרות? ואיך כלים תומכים כמו טבליות קסימינל יכולים לסייע בתהליך העדין הזה? המדריך הזה נועד לעשות סדר, להפיג את החששות ולתת לך תוכנית פעולה ברורה, מדויקת ומבוססת מדע.
שני פסים! מה המשמעות של בדיקת ביוץ חיובית ומה עושים עכשיו?
הופעתם של שני הפסים מעוררת תחושת דחיפות, אך חשוב להבין בדיוק מה היא מסמלת. תוצאה חיובית בבדיקת ביוץ אינה אומרת שהביוץ מתרחש בדיוק באותו הרגע. למעשה, הבדיקה מזהה עלייה חדה ברמות הורמון הנקרא הורמון מחלמן (Luteinizing Hormone, או בקיצור LH) בשתן. הורמון זה הוא "המתג" שהמוח מפעיל כדי לשלוח פקודה לשחלות לשחרר ביצית בשלה. זהו האות האחרון לפני האירוע המרכזי.
חשבי על זה כך: העלייה ב-LH היא כמו הודעה שהרכבת עומדת לצאת מהתחנה. היא לא יצאה עדיין, אבל זה עומד לקרות בקרוב מאוד. בדרך כלל, תהליך הביוץ הביולוגי עצמו, כלומר שחרור הביצית מהשחלה אל החצוצרה, יתרחש כ-24 עד 36 שעות *לאחר* קבלת התוצאה החיובית. ההבנה הזו היא המפתח לתכנון נכון של המשך הדרך וניצול חלון ההזדמנויות היקר.
פענוח חלון הפוריות: המדריך המדעי לתזמון מושלם
"חלון הפוריות" הוא המונח המתאר את מספר הימים בכל מחזור חודשי שבהם קיום יחסים יכול להוביל להריון. זה לא יום אחד, אלא תקופה של כמה ימים. הסיבה לכך נעוצה בהבדלים ב"אורך החיים" של תאי הזרע והביצית. בעוד הביצית שורדת רק כ-12 עד 24 שעות לאחר הביוץ, תאי הזרע יכולים לשרוד בתוך גוף האישה בתנאים מתאימים עד חמישה ימים.
הנתון הזה משנה את כל התמונה. הוא אומר שהתזמון האידיאלי לקיום יחסים הוא לא רק ביום הביוץ עצמו, אלא גם בימים שלפניו. קיום יחסים לפני הביוץ מאפשר לזרע "לחכות" בסבלנות בחצוצרות עד להגעתה של הביצית. לכן, בדיקת הביוץ החיובית היא קריאת השכמה קריטית שמסמנת את פתיחתו של החלק הפורה ביותר בחלון הזה.
המלצה ברורה לתזמון יחסים לאחר בדיקה חיובית:
- היום של הבדיקה החיובית: זהו זמן מצוין לקיים יחסים. הזרע יגיע וימתין לביצית שתשתחרר בקרוב.
- היום שאחרי הבדיקה החיובית: זהו היום בעל הסיכויים הגבוהים ביותר, וכנראה יום הביוץ עצמו. מומלץ מאוד לקיים יחסים גם ביום זה.
- יומיים אחרי הבדיקה החיובית: הסיכויים כבר נמוכים יותר מכיוון שהביצית כנראה כבר סיימה את חייה הקצרים, אך עדיין קיימת אפשרות מסוימת.

כיצד קסימינל (Xyminal) יכול לסייע בתהליך?
כעת, לאחר שהבנו את חשיבות התזמון, נשאלת השאלה האם יש דרך נוספת לתמוך בתהליך וליצור סביבה אופטימלית להפריה. כאן נכנסות לתמונה טבליות קסימינל (Xyminal). חשוב להדגיש: קסימינל אינו תרופת פלא, אלא כלי עזר מבוסס מדע שנועד לתמוך בתנאים הטבעיים של הגוף ולסייע ביצירת סביבה וגינלית ידידותית יותר לתאי הזרע.
הרציונל מאחורי המוצר פשוט וחכם. הסביבה הטבעית בנרתיק היא חומצית (עם רמת pH נמוכה). חומציות זו חיונית להגנה מפני זיהומים וחיידקים לא רצויים. עם זאת, סביבה חומצית מדי עלולה להיות עוינת לתאי הזרע, לפגוע בתנועתיות שלהם ולהקשות עליהם לשרוד את המסע לעבר הביצית. טבליות קסימינל (Xyminal), המכילות רכיבים שנחקרו כמו מיואינוסיטול, מתמוססות בנרתיק ומסייעות באיזון זמני של רמת החומציות, והופכות את הסביבה לבסיסית יותר (pH גבוה יותר) למשך זמן קיום היחסים. סביבה זו מיטיבה עם תאי הזרע, תומכת בשרידותם ומשפרת את תנועתיותם, ובכך מסייעת להגדיל את הסיכוי שאחד מהם יגיע למטרה.
פרוטוקול שימוש מדויק בקסימינל: צעד אחר צעד
כדי להפיק את המרב מהסיוע שקסימינל מציע, יש להשתמש בו בצורה מתוזמנת ומדויקת, בהתאם לחלון הפוריות שאיתרת. שימוש נכון יבטיח שהסביבה בנרתיק תהיה אופטימלית בדיוק ברגעים הקריטיים. ב'טראסטפארם בע"מ', אנו מאמינים במתן הנחיות ברורות המבוססות על היגיון ביולוגי כדי להעצים את המשתמשות שלנו. הנה פרוטוקול השימוש המומלץ, שלב אחר שלב:
| שלב | תזמון | פעולה | הסבר |
|---|---|---|---|
| זיהוי חלון הפוריות | החל מהיום ה-11 למחזור (במחזור של 28 יום), או בהתאם להוראות ערכת הבדיקה שלך | התחילי להשתמש בבדיקות ביוץ יומיות. | המטרה היא לאתר במדויק את קפיצת הורמון ה-LH, שמסמנת את תחילת 36 השעות הפוריות ביותר. |
| בדיקה חיובית | ביום קבלת התוצאה החיובית | החדירי טבלית קסימינל אחת לעומק הנרתיק, כ-10 דקות לפני קיום יחסים. | הטבליה מתמוססת במהירות ויוצרת סביבה מיטבית עם רמת pH מאוזנת לקליטת הזרע. |
| יום הביוץ המשוער | ביום למחרת הבדיקה החיובית | החדירי טבלית קסימינל נוספת כ-10 דקות לפני קיום יחסים. | זהו היום שבו הביוץ צפוי להתרחש, ולכן חשוב למקסם את הסיכויים גם בו. |
| לאחר הביוץ | הימים שלאחר מכן | אין צורך להמשיך להשתמש בקסימינל עד למחזור הבא. | המוצר מיועד לשימוש ממוקד סביב הביוץ. לאחר שחלון הפוריות נסגר, אין יתרון בשימוש נוסף. |

שאלות נפוצות ותשובות מומחים
הדרך להורות מלווה בהרבה שאלות. ריכזנו עבורכן את השאלות הנפוצות ביותר בנוגע לבדיקות ביוץ והשימוש בקסימינל, עם תשובות ברורות ממומחי טראסטפארם בע"מ, הדור הבא של חברות התרופות.
האם אפשר להשתמש בקסימינל יותר מפעם אחת ביום?
ההמלצה היא לפעול לפי ההוראות ולהשתמש בטבליה אחת לפני כל אקט של קיום יחסים המתוכנן בתוך חלון הפוריות (ביום הבדיקה החיובית וביום שאחריו). אם אתם מתכננים לקיים יחסים יותר מפעם אחת ביממה, ניתן להשתמש בטבליה נוספת לפני הפעם השנייה. אין יתרון בשימוש עודף או בשימוש בטבליות שלא בסמוך לקיום יחסים.
קיבלתי פס חלש בבדיקה, האם זה חיובי?
לא. תוצאה חיובית ברוב המכריע של בדיקות הביוץ מוגדרת כאשר פס הבדיקה (הפס המשתנה) כהה לפחות כמו פס הביקורת (הפס הקבוע), או אפילו כהה יותר. פס חלש יותר מפס הביקורת מעיד על נוכחות מסוימת של הורמון LH, אך לא על הקפיצה החדה שמבשרת את הביוץ הקרב. במקרה כזה, יש להמשיך ולבצע בדיקה יומית. למידע נוסף ומפורט, ניתן לקרוא מידע נוסף על בדיקות ביוץ באתרים רפואיים מהימנים.
האם יש תופעות לוואי לשימוש בקסימינל?
קסימינל מבוסס על רכיבים שנחקרו והוא נחשב בטוח לשימוש וגינלי. הרכיבים נבחרו בקפידה כדי לתמוך בסביבה הטבעית מבלי לגרום לגירוי. עם זאת, כמו בכל מוצר, במקרה נדיר של רגישות אישית, אי נוחות או תגובה אלרגית, יש להפסיק את השימוש ולהתייעץ עם רופא. חשוב לציין: קסימינל אינו אמצעי מניעה ואינו מגן מפני מחלות המועברות במגע מיני.
קיימנו יחסים יום לפני הבדיקה החיובית, פספסנו?
ממש לא, להפך! זהו תזמון מצוין. כפי שהסברנו, תאי הזרע יכולים לשרוד בגוף האישה עד 5 ימים. קיום יחסים ביום שלפני קבלת התוצאה החיובית מבטיח שכבר יהיו תאי זרע שממתינים לביצית כשתשתחרר. למעשה, קיום יחסים לסירוגין בימים המובילים לביוץ נחשב לאסטרטגיה יעילה מאוד.
סיכום ומסר של תקווה
המסע לקראת הריון הוא אישי, ייחודי ולעיתים גם מאתגר. הבנת התהליכים הביולוגיים המתרחשים בגופך היא כלי רב עוצמה שמעניק לך שליטה ותחושת ביטחון. קבלת בדיקת ביוץ חיובית היא נקודת ציון מרגשת, וכעת את יודעת בדיוק כיצד לפענח אותה וכיצד לפעול. זכרי את הנקודות המרכזיות: הבדיקה החיובית מראה שהביוץ יתרחש תוך 24-36 שעות, התזמון המדויק של יחסי המין הוא קריטי, וכלים תומכים כמו קסימינל יכולים לסייע ביצירת סביבה מיטבית להצלחה.
הידע שרכשת הוא הכוח שלך. את לא לבד בתהליך הזה, וישנם פתרונות מבוססי מדע שיכולים לתמוך בך. מוכנה לקחת את הצעד הבא ולתמוך בתהליך באופן טבעי ומבוסס מדע? לחצי כאן למידע נוסף ולרכישת טבליות קסימינל. ואם תרצי להמשיך ולהעמיק בנושאים נוספים של בריאות האישה ופוריות, את מוזמנת תמיד לקרוא עוד מאמרים בבלוג שלנו.